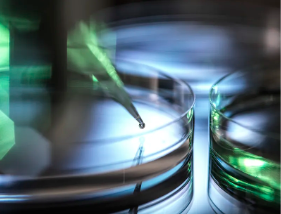
image.png

干細胞治療腦癱費用和技術(shù)解讀?
2024-10-25 13:36:05 來源: 小編 咨詢醫(yī)生
干細胞治療作為一種新型生物治療手段,近年來在神經(jīng)系統(tǒng)疾病領(lǐng)域取得了顯著成果。腦癱,全稱為腦性癱瘓,是一種常見的神經(jīng)系統(tǒng)疾病,嚴重影響患者的生活質(zhì)量。下面我們就來了解一下干細胞治療腦癱的費用和技術(shù)。
一、干細胞治療腦癱的費用
干細胞治療腦癱的費用因地區(qū)、醫(yī)院、治療方案等因素而異。在我國,干細胞治療腦癱的費用大致分為以下幾個方面:
1.診斷費用:包括患者的檢查、評估、確診等費用,一般在幾千到幾萬元不等。
2.治療費用:包括干細胞制備、移植、康復(fù)訓(xùn)練等費用,一般在10萬元左右。具體費用根據(jù)患者病情、治療方案和醫(yī)院收費**而定。
3.康復(fù)費用:患者在接受干細胞治療后的康復(fù)訓(xùn)練費用,根據(jù)訓(xùn)練周期和康復(fù)項目不同,費用在幾千到幾萬元不等。
二、干細胞治療腦癱的技術(shù)解讀
1.干細胞來源:用于治療腦癱的干細胞主要來源于自體脂肪、骨髓、外周血等。自體脂肪來源的干細胞具有較強的分化能力和較低的免疫排斥風(fēng)險。
2.干細胞制備:將采集到的干細胞進行分離、純化、擴增等處理,使其具備足夠的數(shù)量和質(zhì)量,以滿足治療需求。
3.干細胞移植:將制備好的干細胞通過靜脈注射、鞘內(nèi)注射等方式植入患者體內(nèi),使其在體內(nèi)分化為神經(jīng)元、膠質(zhì)細胞等,修復(fù)損傷的神經(jīng)系統(tǒng)。
4.康復(fù)訓(xùn)練:患者在干細胞移植后,需要接受系統(tǒng)的康復(fù)訓(xùn)練,包括物理治療、作業(yè)治療、言語治療等,以促進神經(jīng)功能的恢復(fù)。
5.安全性:干細胞治療腦癱具有較高的安全性,但仍有少數(shù)患者可能出現(xiàn)不良反應(yīng),如感染、過敏等。因此,在選擇干細胞治療時,患者應(yīng)充分了解治療方案和可能的風(fēng)險。
總之,干細胞治療腦癱作為一種前沿的生物治療手段,具有很大的發(fā)展?jié)摿?。雖然治療費用相對較高,但相較于其他治療方法,其效果和安全性更具優(yōu)勢?;颊咴谶x擇干細胞治療時,應(yīng)充分了解相關(guān)信息,并在專業(yè)醫(yī)生的指導(dǎo)下進行。
- 2024-12-02干細胞療法中國有嗎,治療費用大概是多少
- 2024-10-19張愛民干細胞療法的效果與評價如何?
- 2024-10-31視網(wǎng)膜色素變性如何利用干細胞治療?
- 2024-09-02干細胞治療成功治愈率高嗎,干細胞治療疾病徹底嗎
- 2024-10-16膝蓋干細胞療法真的有效嗎?患者評價如何?
- 2024-08-29打一針干細胞能管幾年,對身體有什么好處和壞處
- 2024-07-22干細胞移植費用大概多少錢,干細胞移植治療哪些病
- 2024-09-14干細胞治帕金森費用多少,附原理效果
- 2024-08-04干細胞與抗衰老,干細胞抗衰老是不是騙局
- 2024-09-04干細胞注射治療截癱效果如何多少錢
- 2024-10-05湖北干細胞作用有哪些?如何選擇干細胞治療方案?
- 2024-08-22干細胞治療腎炎怎么樣,作用原理是什么
- 2024-09-05干細胞移植治療腦梗塞效果好嗎,干細胞可以治療腦梗嗎
- 2024-08-19干細胞軟骨修復(fù)過程,修復(fù)價格多少
- 2024-09-13干細胞移植排異期多久,如何應(yīng)對排異反應(yīng)
- 2024-09-23307醫(yī)院干細胞移植怎么樣,內(nèi)附費用明細
- 2024-07-22打一針干細胞能管幾年,打一針干細胞多少錢
- 2024-09-06干細胞具有什么功效,詳解主要功效和副作用
